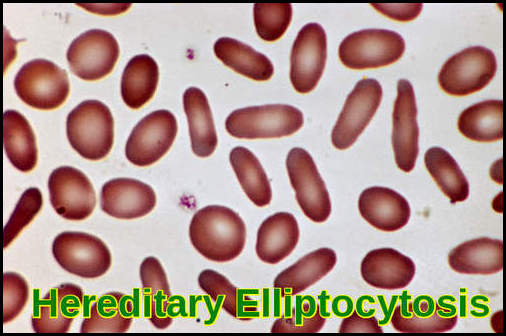
Hereditary Elliptocytosis (Ovalocytosis) – elliptocytes and ovalocytes on blood smear Peripheral blood smear demonstrating both elliptocytes and ovalocytes characteristic of hereditary elliptocytosis/ovalocytosis.

Elliptocytosis
Understanding Hereditary Elliptocytosis (HE): A Defect of the Red Cell Membrane

Blood smear in hereditary elliptocytosis demonstrating multiple elliptocytes characteristic of this red-cell membrane disorder.
Hereditary Elliptocytosis (HE), or ovalocytosis, is defined as a genetic disorder of the red cell membrane that affects the shape of red blood cells. Characterized by the presence of a majority of elliptical-shaped cells on the peripheral smear, HE results from specific mutations in cytoskeletal genes, notably spectrin (SPTA1, SPTB), protein 4.1 (EPB41), and band 3 (SLC4A1). HE is inherited usually in an autosomal dominant pattern but since penetrance is variable and many carriers remain asymptomatic, establishing the correct diagnosis relies on combining clinical findings with molecular and morphological evidence.
- HE is due to defects in either the structure or quantity of the cytoskeletal proteins responsible for maintaining the biconcave morphology of RBCs. Mutations in either alpha- and beta-spectrin are most commonly responsible, but mutations in other cytoskeletal proteins (band 4.1 and glycophorin) are also described.
- Elliptocytosis affects about 1 in every 2,500 people of northern European heritage. It is more common in people of African and Mediterranean descent.
- Most affected individuals are asymptomatic, though mild anemia, jaundice, splenomegaly, and leg ulcers can occur. Laboratory studies may show evidence of hemolysis, such as low haptoglobin levels; a high reticulocyte count; and elevated concentrations of lactic dehydrogenase (LDH) and indirect bilirubin. It is important to emphasize that the percentage of elliptocytes observed does not correlate with the severity of hemolysis. Ultrasound of the gallbladder may show gallstones.
- The diagnosis of hereditary elliptocytosis is usually made by coupling a family history of the condition with an appropriate clinical presentation and confirmation on a blood smear. In general, it requires that at least 25% of erythrocytes in the specimen are abnormally elliptical in shape (cigar-shaped) though the observed percentage of elliptocytes can be 100%. This is in contrast to the rest of the population, in which it is common for up to 15% of erythrocytes to be elliptical. Results of osmotic fragility testing are within reference ranges in typical HE, but values are increased in spherocytic HE.
Blood film in hereditary elliptocytosis displaying abundant ovalocytes and elliptocytes typical of this red-cell membrane disorder.
- The vast majority of those with hereditary elliptocytosis require no treatment whatsoever. They have a mildly increased risk of developing gallstones, which is treated surgically with a cholecystectomy if the pain becomes problematic. Folate helps to reduce the extent of anemia in those with significant hemolysis due to hereditary elliptocytosis.
- Splenectomy is only considered in severe symptomatic cases.
- Elliptocytes can occur in many other conditions (eg, iron deficiency, leukemias, megaloblastic anemias, myeloproliferative diseases, myelodysplastic syndromes) but usually do not reach the proportions observed in patients with HE.
Prognosis:
The prognosis for individuals with elliptocytosis varies, with many leading normal and healthy lives. However, the severity of symptoms and complications can differ among affected individuals. Regular monitoring and appropriate medical intervention are crucial to managing the condition effectively.
Conclusion:
Elliptocytosis is a rare yet intriguing genetic disorder affecting red blood cells. While it poses challenges in terms of diagnosis and management, advancements in genetic research and medical interventions continue to enhance our understanding and treatment options for individuals with this condition. A multidisciplinary approach involving hematologists, geneticists, and other specialists is essential for comprehensive care and support.
Questions and Answers:
What is hereditary elliptocytosis?
Hereditary elliptocytosis is an inherited red-cell membrane disorder caused by defects in spectrin, protein 4.1, or glycophorin C, leading to elliptical or oval-shaped erythrocytes on the blood film.
What causes elliptocytes to form in hereditary elliptocytosis?
Elliptocytes form due to impaired cytoskeletal stability, most commonly from mutations affecting spectrin dimer–dimer interaction or protein 4.1R, which prevents normal red-cell deformability.
What symptoms suggest hereditary elliptocytosis?
Most individuals are asymptomatic, but some may develop mild anaemia, jaundice, neonatal hyperbilirubinaemia, splenomegaly, or episodic haemolysis, especially during infections.
How is hereditary elliptocytosis diagnosed?
Diagnosis relies on peripheral smear showing >25–60% elliptocytes, supported by EMA binding test, osmotic fragility, ektacytometry, and molecular testing for membrane protein defects when needed.
What is the treatment for hereditary elliptocytosis?
Most cases require no treatment; supportive care is typical. Folate supplementation and splenectomy are reserved for transfusion-dependent or haemolytic variants such as hereditary pyropoikilocytosis.
Is hereditary elliptocytosis the same as ovalocytosis?
Both conditions show elongated cells, but Southeast Asian ovalocytosis (SAO) is a distinct entity caused by a band 3 mutation, producing rigid ovalocytes with central stomal defects and malaria resistance.
Can hereditary elliptocytosis cause severe haemolysis?
Severe haemolysis is uncommon but can occur in hereditary pyropoikilocytosis or compound heterozygous states. These variants present with marked poikilocytosis and transfusion needs.
Should family members be tested for hereditary elliptocytosis?
Screening is reasonable for first-degree relatives, particularly if there is anaemia, neonatal jaundice, or a known autosomal dominant pattern in the family.
References:
Gallagher PG. (2011). Hemolytic Anemias: Red Cell Membrane and Metabolic Defects. In: Goldman L, Schafer AI (eds). Cecil Medicine, 24th ed. Philadelphia, PA: Saunders Elsevier; Chapter 164.
Da Costa L., Galimand J., Fenneteau O., Mohandas N. (2013). “Hereditary spherocytosis, elliptocytosis, and other red cell membrane disorders.” Blood Reviews, 27(4): 167-178.
King MJ., Garçon L., Hoyer JD., Iolascon A., Picard V., Stewart G., et al. (2015). “ICSH guidelines for the laboratory diagnosis of non-immune hereditary red cell membrane disorders.” International Journal of Laboratory Hematology, 37(3): 304-325.
Jha SK., Vaqar S. (2024). Hereditary Elliptocytosis. StatPearls [Internet]. Available at: https://www.ncbi.nlm.nih.gov/books/NBK562333/
Zaidi AU., Buck S., Gadgeel M., Herrera-Martinez M., Mohan A., Johnson K., Bagla S., Ravindranath Y. (2020). “Clinical diagnosis of red cell membrane disorders: comparison of osmotic gradient ektacytometry and EMA fluorescence test for red cell band 3 content.” Frontiers in Physiology. DOI:10.3389/fphys.2020.00636
Keywords:
elliptocytosis, hereditary elliptocytosis, ovalocytosis, elliptocytosis symptoms, elliptocytosis causes, elliptocytosis treatment, elliptocytosis anemia, elliptocytosis diagnosis, elliptocytosis management, elliptocytosis vs ovalocytosis, what is elliptocytosis, what are elliptocytes, elliptocytes in anemia, significance of elliptocytes, red cell membrane disorder, spectrin mutation, splenectomy for elliptocytosis, spherocytic elliptocytosis, osmotic fragility test, elliptocytosis prognosis, elliptocytosis genetics, elliptical red blood cells, HE red cell disorder








My 18 year old son is suffering from ellyptocytodid. At present he has no health problem. May I have to take any precaution or treatnent
Hello,
Thank you for contacting me. Generally speaking, most patients with hereditary elliptocytosis (HE) do not require medical treatment. A diet rich in folic acid or folic acid supplementation is recommended to avoid consequences of folate deficiency in a hemolytic state. Other supportive measures, such as blood transfusions, may be indicated if the anemia is severe. Splenectomy markedly improves anemia for patients with clinically significant hemolysis. Splenectomy stops or markedly reduces hemolysis that results from HE but does not correct the underlying membrane defect. As long as your son’s hemoglobin is stable and he has no frequent hemolytic crisis he will not require any treatment.
Best wishes,
Author
Wife has a long history of severe hereditary elipticsitosis. Her spleen and gal bladder were removed in 1977. We always have trouble finding dermatologist knowledgeable with this disorder. Only one, at UM Ann Arbor, was any help. One in Memphis, TN, who knew of it. Seems like she is going through a crisis right now, and we’d like to talk to a knowledgeable doctor. Her bruising seems worse than usual, and she seems to be having dots on her body. Would you email me with a list of knowledgeable doctors? Thank you
I have a question? Does a hemoglobin of 13 and an iron sat of 14% show Elliptpcytes +1 in morphology? IDA is present going on 3rd set of iron infusions.
Hi Drea,
Thank you for reaching out.
The presence of elliptocytes (+1) on a peripheral blood smear in this context is not unusual.
Elliptocytes are commonly seen in iron deficiency anemia, typically in mild to moderate numbers.
BW,
Dr M Abdou